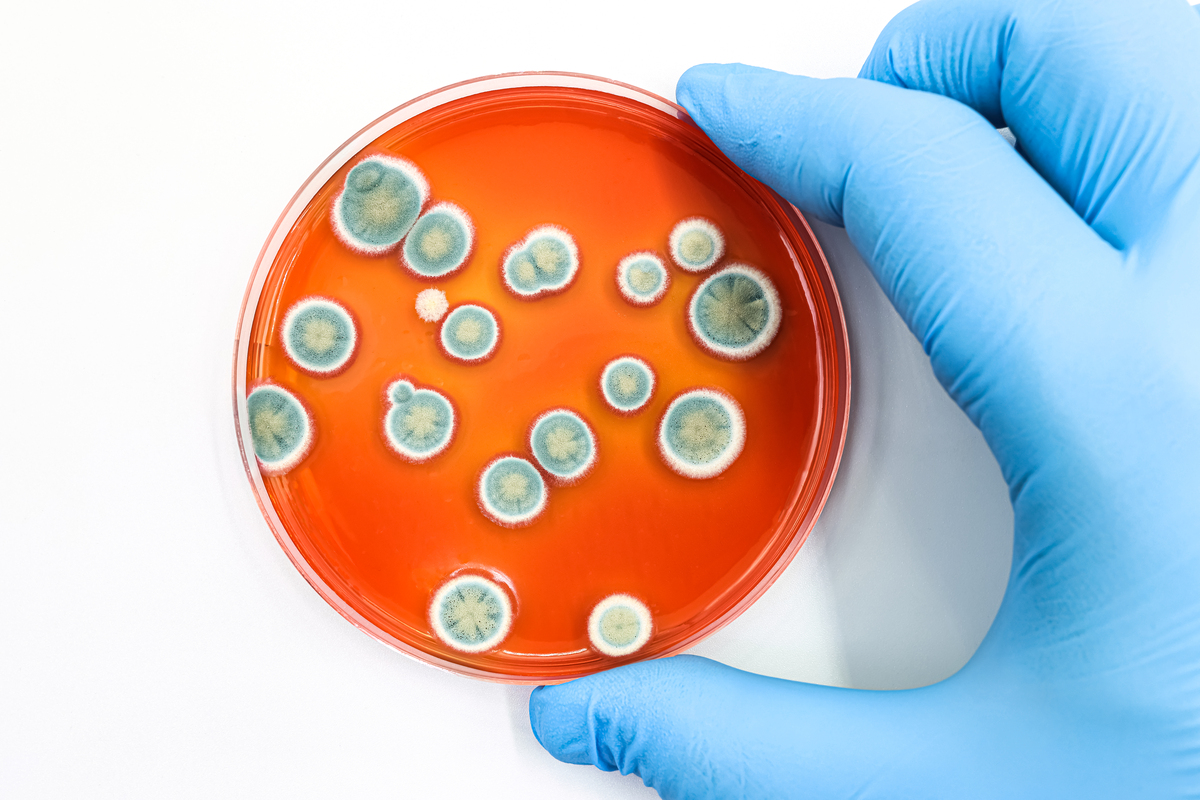
制药微生物科工作内容介绍：职责、技能要求和未来发展

制药微生物科工作内容介绍:职责、技能要求和未来发展
很棒!'制药微生物科'是一个非常重要的领域,它涉及到制药过程中的微生物技术应用,包括发酵、分离、纯化以及微生物检测等方面。在这个领域工作需要具备扎实的微生物学、生物化学和制药工程等知识,同时也需要具备实验技能和严谨的工作态度。希望你在这个领域里能够不断学习和成长,为制药行业做出更多的贡献!

原文地址: https://www.cveoy.top/t/topic/m8zK 著作权归作者所有。请勿转载和采集!
安全问答是一个知识全球问答,包含丰富的问答知识
很棒!'制药微生物科'是一个非常重要的领域,它涉及到制药过程中的微生物技术应用,包括发酵、分离、纯化以及微生物检测等方面。在这个领域工作需要具备扎实的微生物学、生物化学和制药工程等知识,同时也需要具备实验技能和严谨的工作态度。希望你在这个领域里能够不断学习和成长,为制药行业做出更多的贡献!
原文地址: https://www.cveoy.top/t/topic/m8zK 著作权归作者所有。请勿转载和采集!